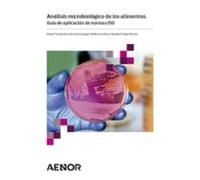
Análisis Microbiológico De Alimentos. Guía De Aplicación Normas Iso Gu

- 1
- 2
- 3
- 4
- 5
- página siguiente
🤖 Pregunta a ChatGPT
Información acerca de "aplicación de normas"
Si buscas los precios más baratos del mercado, en nuestro portal puedes confrontar 468 precios para el producto que te interesa.
Comparar.net ha encontrado una gran variedad de artículos en 39 categorías diferentes. Su precio se encuentra entre 3,08 € y 3.630,00 €.
Datos de "aplicación de normas"
- Consulta los mejores precios de 15 tiendas web diferentes, como Amazon Marketplace (ES), tameson.es, amazon.es y casadellibro.com.
- Si quieres seleccionar un producto solo por producto,lo encontrarás en 14 vendedores. Si te cuesta decidirte, puedes filtrar los resultados por marcas que más te gusten y decidir entre Wago, LEGO, Michelin y Engwe.
- La mayoría de ofertas se han encontrado con un precio aproximado de 9,00 € - 9,99 €
- Algunos usuarios también han consultado estos productos similares: .
- Aquellos compradores cansados del negro pueden elegir entre una gran variedad de tonos para dar una nota de alegría a sus productos. La paleta de colores cuenta con hasta 17 entre los que elegir.